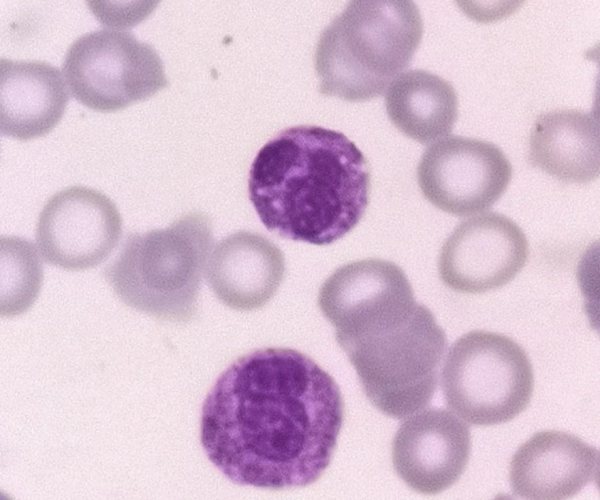
一例慢性中性粒細胞白血病病例分享

單位 | 中山市博愛醫院
案例經過
患者,女,69歲,2018年發現白細胞升高,經過基因測序被診斷為“慢性骨髓增殖性腫瘤”,2019年查骨髓細胞學:骨髓增生明顯活躍、以粒系和巨核細胞增生為主、嗜酸嗜鹼細胞可見、血小板少見,外周血以粒係為主(其中桿狀核+分葉核粒細胞佔總數的83.0%)可見幼紅、幼粒。
2021年因“血尿、乏力、腹脹三年餘”等情況再次入院,入院體格檢查如下:神智清晰、營養欠佳、對答切題、貧血貌、面板粘膜吳黃染及出血點、鞏膜無黃染、全身淺表淋巴結未及腫大。
咽無充血、扁桃體無腫大、雙肺呼吸音清、未聞及乾溼囉音;心界不大、心率98次/分、律齊、各瓣膜聽診區未聞及病理性雜音;腹飽滿、全腹無壓痛、無反跳痛、脾肋下10cm,質硬,肝腎區無壓痛、叩擊痛,移動性濁音陽性,腸鳴音正常。雙下肢對稱性輕度水腫。四肢無力、肌張力正常。生理反射存在,病理反射未引出。
患者檢查結果如下:
骨髓活檢結果:骨髓有核細胞增生明顯活躍,粒紅比增大,未見典型ALIP及熱點現象;粒系增生,以偏成熟階段細胞為主;紅系各階段細胞均可見,以中晚幼紅細胞為主;巨核細胞數量在正常範圍,以分葉核巨核細胞為主;淋巴細胞散在分佈;骨髓間質未見明顯教員纖維化,未見骨硬化。
免疫組化結果:CD34散在少(+),CD117散在少(+),CD61巨核細胞(+),CD3散在(+),CD20散在少(+),CD138散在(+),Ki-67(30%+)。
染色體核型:46,XX20
基因測序:CALR,SRSF2,JAK2-V617F,JAK2-外顯子12&13,MPL,ASXL1,CSF3R-外顯子14&17均為陰性。
MPN常見基因突變篩查:ASXL1,CALR,CBL,DNMT3A,EZH2,IDH1,IDH2均為陰性。
MDS/MPN基因突變檢測:NOTCH1(+)
FISH:-8/+8、-7/7q-,D2OS108,EGR1(5q31),P53(17p13,1)均為陰性。
PCT結果:1.53
案例分析
患者經過基本治療後的檢查結果:
【診斷推測】
患者常規檢查中有白細胞異常增高,且長時間有乏力、腹痛的現象,經過入院治療後依舊未改善,後發現腹嘭隆,脾肋下10cm質硬,移動性濁音可疑陽性,其餘心肺腹查體無特殊。
在外周血塗片細胞檢查中發現白細胞數均>25×109/L,中性分葉核和桿狀核細胞>80%,幼稚細胞<10%,原始粒細胞罕見,單核細胞<1×109/L,中性粒細胞無病態造血。且在中性粒細胞中可以發現有異常的粗大毒性顆粒和杜勒小體。紅細胞和血小板的形態皆正常。
骨髓活檢可發現有核細胞過度增生,中性粒細胞增多,粒紅比例異常的高。各系細胞均無發育異常,網狀纖維增生未見。
中性粒細胞持續升高時間大於3個月,脾腫大,且沒有可以識別的反應性中性粒細胞升高的原因,遺傳學方面除MDS/MPN基因突變檢測發現NOTCH1陽性外,並沒有發現其他異常的基因重排、突變和融合現象。
【確診結果】
臨床診斷:慢性中性粒細胞白血病。
討論與心得
慢性中性粒細胞白血病(CNL)是少見的慢性白血病,病程較長,程度較輕,診斷較複雜,易與其他型別的白血病和類白血病反應相混淆。白細胞數、中性成熟粒細胞持續明顯增多,可見少數幼稚粒細胞及其毒性樣顆粒等形態改變以及NAP活性顯著增高,Ph1染色體陰性等與類白血病反應極為相似。
但類白血病反應有明確病因。類白血病反應有原發病的臨床表現,針對病因治療後血常規可在短期內恢復,二者的鑑別主要基於臨床檢查,治療病因後可恢復正常。慢性中性粒細胞白血病病程時間長,白細胞數及中性分葉核粒細胞數長期處於高水平[1]。嗜酸性或嗜鹼性粒細胞不增多或缺乏,紅系極度受抑,會伴有感染骨髓象,只是紅系較少[2]。
CNL主要是以不明原因的成熟中性粒細胞持續增多、脾臟增大、骨髓中粒系過度增生但不伴有發育異常及顯著的骨髓纖維化、無Ph 染色體及BCR/ABL1融合基因為主要特點[3]。診斷標準如下:
根據該患者多次血常規白細胞數和中性粒細胞比例,繪製出折線圖,可直觀的看出白細胞和中性粒細胞數目的變化。該患者的中性粒細胞比例一直沒有下降的趨勢,在用了抗感染藥之後也是一樣平緩;白細胞數在用藥治療解決了感染問題後雖然出現了一次大幅度的下降,但依舊高於25×109/L。加上前面出現的脾腫大等臨床表現和外周血、骨髓細胞檢查,基本符合2016年WTO制定的慢性中性粒細胞白血病診斷標準。因此可以診斷該患者是慢性中性粒細胞白血病。
CNL是一種罕見的BCR-ABL陰性的骨髓增值性腫瘤,2001年WHO造血和淋巴組織腫瘤分型中才作為獨立疾病得到正式的認定。2013年發現CSF3RT618I突變是CNL一個高度特異性而敏感的分子診斷標誌。從而CNL的診斷不再是排除性診斷。
CSF3R除最常見的T618I突變,其它少見突變尚有T615A和T640N。疑似CNL的患者應進行前述基因突變篩查,以尋找疾病克隆性證據[4]。若在工作中發現中性粒細胞持續性增長,肝脾大,中性粒細胞NAP超過300,雖無CSF3R突變,可採取跟蹤性動態觀察與實驗結果明確診斷。
參考文獻
[1]邱春紅,丘春東.3例慢性中性粒細胞白血病與類白血病反應鑑別診斷分析[J]重慶醫學.2009年9月第38卷第18期
[2]陳石,李德高.慢性中性粒細胞白血病診斷討論[J].臨床血液雜誌.2007(05)
[3]郭玉潔,王豔,王立華,等.慢性中性粒細胞白血病患者的臨床特徵及預後分析[J]中國實驗血液雜誌.2020,28(1):82-87
[4]肖志堅.血液病診斷及療效標準[M](第4版):137-138